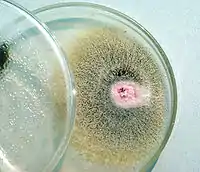

Фузарій
Фузарій (Fusarium) — великий рід філаментарних аскомікотових грибів (Ascomycota), широко розповсюджених у ґрунті та в асоціації з рослинами.
? Fusarium | ||||||||||||||||||||
|---|---|---|---|---|---|---|---|---|---|---|---|---|---|---|---|---|---|---|---|---|
![]() Fusarium verticillioides | ||||||||||||||||||||
| Біологічна класифікація | ||||||||||||||||||||
| ||||||||||||||||||||
| Fusarium roseum Link, 1809 | ||||||||||||||||||||
Посилання | ||||||||||||||||||||
| ||||||||||||||||||||
Опис

_Wollenw._5359729.jpg.webp)
Грибниця переважно розвивається в субстраті, іноді — на його поверхні. Розмножується конідіями, хламідоспорами, лише деякі види роду мають сумчасте спороношення. Іноді у фунгаріїв утворюються склероції. Спорофіти.
Поширення
Поширені по всій земній кулі, крім Антарктиди.
Значення
Більшість видів є безпечними сапрофітами та відносно поширені серед мікрофлори ґрунту. Багато видів спричинюють у рослин захворювання — фузаріози. Деякі види виробляють мікотоксини (наприклад фумонізіни і трихотецени), зокрема в зернових культурах, і можуть шкідливо впливати на здоров'я людини та інших тварин. Низка видів є паразитами тварин, зокрема комах. Деякі, наприклад F. sporotrichioides, розвиваються на зерні, що перезимувало в полі. При вживанні такого зерна виникає тяжке захворювання — алейкія аліментарно-токсична.
Види
База даних Species Fungorum станом на 23.10.2019 налічує 288 видів роду Fusarium[1] (докладніше див. Список видів роду фузарій).
Примітки
- Список видів роду Fusarium. Species Fungorum. Процитовано 23.10.2019.
Джерела
- Українська радянська енциклопедія : у 12 т. / гол. ред. М. П. Бажан ; редкол.: О. К. Антонов та ін. — 2-ге вид. — К. : Головна редакція УРЕ, 1974–1985.

